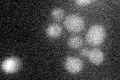
YJL210W
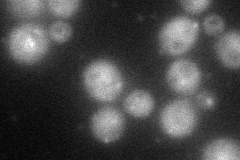
YJL210W
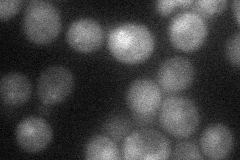
YJL210W
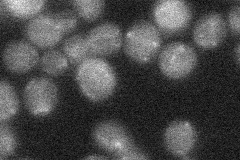
YJL210W
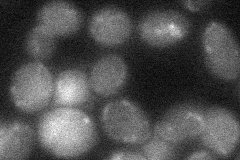
YJL210W
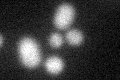
YJL210W
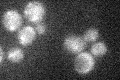
YJL210W

View description
RING-finger peroxin, peroxisomal membrane protein with a C-terminal zinc-binding RING domain, forms translocation subcomplex with Pex10p and Pex12p which functions in peroxisomal matrix protein import
Localization:
Intensity:
Fold change:
Significance:
-
C’ GFP library in SD
below threshold14.09 -
N' NOP1pr-GFP in SD
cytosol,punctate59.1373 -
N' TEF2pr-mCherry in SD
cytosol,punctate20.6583 -
N' NATIVEpr-GFP in SD
below threshold19.5683 -
N' TEF2pr-VC and Cyto-VN in SD
below threshold25.8706 -
C’ GFP library in SD+DTT
cytosol15.291.08No -
C’ GFP library in SD+H2O2
cytosol13.560.96No -
C’ GFP library in Starvation Media

cytosol17.351.23No -
C’ GFP library on the background of Pup2-DaMP

N/A -
C’ GFP library on the background of CCT mutant

N/A0N/AYes
